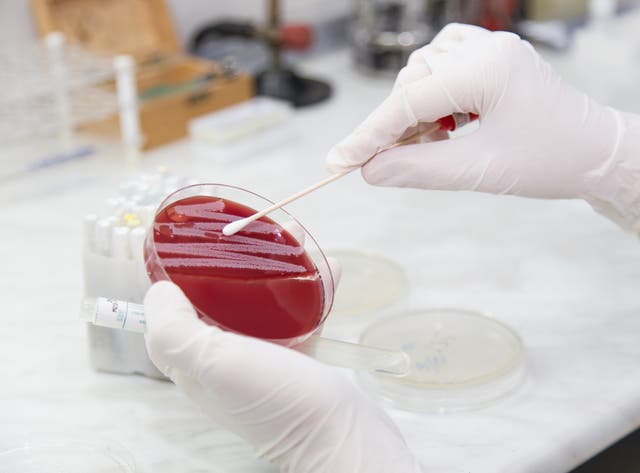

Scientists sequence the complete human genome for the first time
In 2003, the Human Genome Project made history when it sequenced 92% of the human genome. But for nearly two decades since, scientists have struggled to decipher the remaining 8%. Now, a team of nearly 100 scientists from the Telomere-to-Telomere…
31/03/2022 CNN